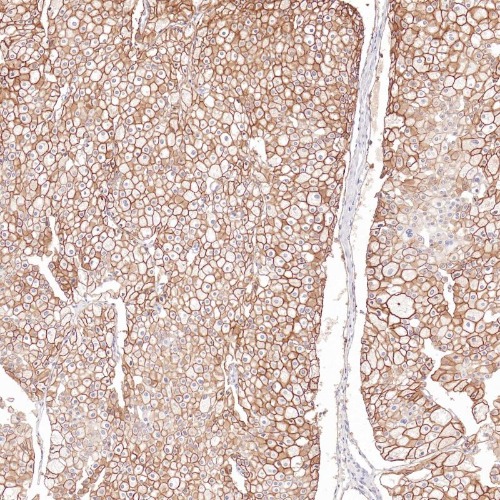

Cadherin 16 Monoclonal Antibody(ARB593)
CAT.NO. : ARB6887
RMB Please choose
RMB Please choose
Size:
Trail, Bulk size or Custom requests Please contact us
*产品价格可能会有所调整,请以品牌方官网实时更新的价格为准,以确保准确性。
Background
Cadherins are calcium-dependent cell adhesion proteins. They preferentially interact with themselves in a homophilic manner in connecting cells. Cadherin 16 is a member of the cadherin family of cell adhesion molecules that is found in the basolateral membrane of renal tubular epithelial cells of the distal tubules and collecting duct. Studies have shown high sensitivity and specificity of Cadherin 16 to chromophobe renal cell carcinoma (RCC) and oncocytoma. Conversely, low reactivity was observed with clear cell RCC and papillary RCC.
Application
|
Application |
Dilution Ratio |
|
IHC-P |
1:100-1:200 |
Overview
|
Predicted Molecular Wt |
90kDa |
|
Species Cross-reactivity |
Human |
|
Applications |
IHC-P |
|
Purity |
ProA affinity purified IgG |
|
Form |
Liquid |
|
SwissProt ID |
O75309 |
|
Subcellular location |
Membrane/cytoplasm |
|
Recommended Method |
Heat induced epitope retrieval with Tris-EDTA buffer (pH 9.0), primary antibody incubate at RT (18℃-25℃) for 30 minutes. |
|
Immunogen |
Synthetic peptide |
|
Storage Buffer |
PBS 59%, Sodium azide 0.01%, Glycerol 40%, BSA 0.05% |
Data
Immunohistochemical staining of chromophobe renal cell carcinoma using Cadherin 16 Monoclonal Antibody(ARB593)
Storage
Store at 4°C short term. For long term storage, store at -20°C, avoiding freeze/thaw cycles.
Research Use Only
For Research Use Only. Not for use in diagnostic procedures.
New Products
